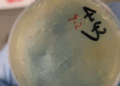

Federal authorities are defying a U.S. District Court judge’s order to release Mahmoud Khalil, a Columbia University activist detained for organizing pro-Palestinian protests, arguing they have found a new legal basis to keep him in custody.
Judge Michael Farbiarz ruled Wednesday that Khalil’s continued detention was likely unconstitutional and ordered the government to either release him or seek intervention from the 3rd Circuit Court of Appeals by Friday morning. Khalil, a lawful permanent resident, has been held since March.
However, federal attorneys responded Friday by claiming they are no longer detaining Khalil under the Immigration and Nationality Act of 1952—a Cold War-era law allowing deportation for foreign policy reasons. Instead, they cited a separate statute that permits detention of immigrants during removal proceedings.
“Detaining Khalil based on that other ground of removal is lawful,” the government argued. “An alien like Khalil may be detained during the pendency of removal proceedings regardless of the charge of removability.”
Khalil’s lawyers pushed back, calling the government’s rationale “false and pretextual.” They urged the court to order his immediate release, but Judge Farbiarz declined.
Khalil remains in ICE custody at a remote facility in Jena, Louisiana—far from his wife and newborn son, with Father’s Day approaching.
“This is a cruel, transparent delay tactic to keep him from his family,” said Amy Greer, a member of his legal team. “Instead of celebrating their first Father’s Day together, he is being punished for his advocacy. It is unjust, it is shocking, and it is disgraceful.”
In April, Secretary of State Marco Rubio issued a memo justifying Khalil’s deportation on the grounds that his involvement in pro-Palestinian protests could have “potentially serious adverse foreign policy consequences for the United States.”
In his ruling, Farbiarz acknowledged that officials might try to justify Khalil’s detention based on allegedly inaccurate information in his green card application, but said that argument rarely leads to detention and appears to be a cover for the more politically motivated rationale.
“That strongly suggests that it is the Secretary of State’s determination that drives the Petitioner’s ongoing detention—not the other charge against him,” Farbiarz wrote.
Khalil has no criminal charges or convictions. His lawyer, Ian Fernando Hinonangan, said the continued detention amounts to unconstitutional retaliation for Khalil’s political speech.
“The post-hoc charge is an undisputed continuation in the fabric of retaliatory motive and hence carries the taint of unconstitutional conduct,” Hinonangan wrote in a declaration Friday.